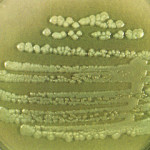

Los investigadores del Hospital Brigham y de Mujeres (BWH) han descubierto una vacuna nueva para la bacteria Pseudomonas aeruginosa aprovechando un nuevo mecanismo de la inmunidad.
Pseudomonas aeruginosa es la principal causa de infecciones adquiridas en hospitales, particularmente en pacientes con respiradores, donde puede causar neumonía llamada asociada a la ventilación, que tiene una tasa de mortalidad muy alta.
Pseudomonas aeruginosa es la principal causa de infecciones adquiridas en hospitales, particularmente en pacientes con respiradores, donde puede causar neumonía llamada asociada a la ventilación, que tiene una tasa de mortalidad muy alta.
Pseudomonas también causa infecciones pulmonares en personas con fibrosis quística, un trastorno genético que hace que los pulmones sean susceptibles a la infección bacteriana.
A pesar de más de 40 años de investigación y desarrollo de vacunas, no existe una vacuna disponible clínicamente para esta bacteria. La mayoría de los esfuerzos de las vacunas anteriores se han centrado en la generación de anticuerpos contra las toxinas de Pseudomonas o moléculas de la superficie, especialmente la capa de azúcar en el insecto llamado el antígeno O del lipopolisacárido. Estos enfoques no han producido una vacuna con licencia para los seres humanos.
Gregorio Priebe, MD, División BWH de Enfermedades Infecciosas, Departamento de Medicina, y la División de Niños de Boston Hospital de Medicina de Cuidados Críticos, Departamento de Anestesiología, perioperatoria y Medicina del Dolor, junto con investigadores de la Harvard Medical School, construyó una vacuna basada en un nuevo mecanismo de la inmunidad a Pseudomonas mediada por T helper 17 (Th17) células. Las células Th17 son un tipo descrito recientemente de células T ayudantes que secretan la citocina IL-17 y mejorar las defensas antibacterianas mucosas.
En los estudios actuales, los investigadores diseñaron una pantalla para antígenos proteicos Th17 estimulantes expresadas por una biblioteca molecular de ADN que codifican proteínas de Pseudomonas. La pantalla descubierto que la proteína Pseudomonas POPB es un estimulador muy eficaz de la inmunidad Th17, y la inmunización con purificó POPB ratones protegidos de la neumonía letal de una manera independiente de anticuerpos.
Los investigadores están tomando su trabajo un paso más allá mediante la construcción de las vacunas conjugadas con POPB como un portador de proteína con la esperanza de mejorar la eficacia de la vacuna. Tienen la esperanza de que la vacuna basada en POPB algún día podría ser usado para prevenir las infecciones por Pseudomonas en pacientes hospitalizados y en personas con fibrosis quística.
pseudomona, pseudomona aeruginosa, pseudomonas, bacteria pseudomona, Pseudomonas aeruginosa, vacuna para pseudomonas aeroginosa






